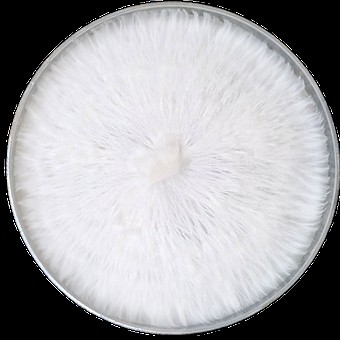
Fully Colonized Agar Plate

Fully Colonized Agar Plate
Our 9mm Fully Colonized Agar Plates are prepared fresh and made to order, ensuring clean, vigorous cultures every time. Each plate is professionally poured, sterilized, and inoculated with the strain of your choice, then incubated until fully colonized — typically within 7–14 days.
These agar plates provide a clean starting point for expansion into grain, liquid culture, or further agar work. They are ideal for isolating genetics, expanding culture collections, or verifying growth before scaling to larger projects.
Choose from a wide range of strains, including classics like Golden Teacher, B+, and PES Amazonian, as well as specialty favorites like Albino Penis Envy, Blue Meanies, Jedi Mind Fuck, Liberty Cap, Matias Romero, Penis Envy, and Flying Saucers.
Key Benefits:
-
✔️ Made to order for peak freshness and colonization
-
✔️ Fully colonized in 7–14 days (varies by strain)
-
✔️ Sterile and professionally prepared
-
✔️ Available in multiple strains to match your research needs
-
✔️ Perfect for culture expansion, transfers, and strain isolation
Backed by More Than Spores quality standards, our agar plates are a reliable foundation for any cultivation workflow.
Our 9mm Fully Colonized Agar Plates are prepared fresh and made to order, ensuring clean, vigorous cultures every time. Each plate is professionally poured, sterilized, and inoculated with the strain of your choice, then incubated until fully colonized — typically within 7–14 days.
These agar plates provide a clean starting point for expansion into grain, liquid culture, or further agar work. They are ideal for isolating genetics, expanding culture collections, or verifying growth before scaling to larger projects.
Choose from a wide range of strains, including classics like Golden Teacher, B+, and PES Amazonian, as well as specialty favorites like Albino Penis Envy, Blue Meanies, Jedi Mind Fuck, Liberty Cap, Matias Romero, Penis Envy, and Flying Saucers.
Key Benefits:
-
✔️ Made to order for peak freshness and colonization
-
✔️ Fully colonized in 7–14 days (varies by strain)
-
✔️ Sterile and professionally prepared
-
✔️ Available in multiple strains to match your research needs
-
✔️ Perfect for culture expansion, transfers, and strain isolation
Backed by More Than Spores quality standards, our agar plates are a reliable foundation for any cultivation workflow.
| Weight | 0.2 lbs |
|---|---|
| Strain | Golden Teacher agar B+ agar Albino Penis Envy agar Blue Meanies agar PES Amazonian agar Jedi Mind Fuck agar Liberty Cap agar Penis Envy agar Matias Romero agar Flying Saucers agar |

Reviews
There are no reviews yet.